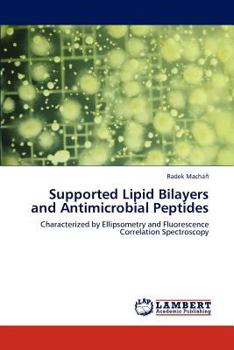
Paperback Supported Lipid Bilayers and Antimicrobial Peptides Book

Supported Lipid Bilayers and Antimicrobial Peptides
No Synopsis Available.
Format:Paperback
Language:English
ISBN:365923575X
ISBN13:9783659235757
Release Date:September 2012
Publisher:LAP Lambert Academic Publishing
Length:72 Pages
Weight:0.26 lbs.
Dimensions:0.2" x 6.0" x 9.0"
Customer Reviews
0 rating